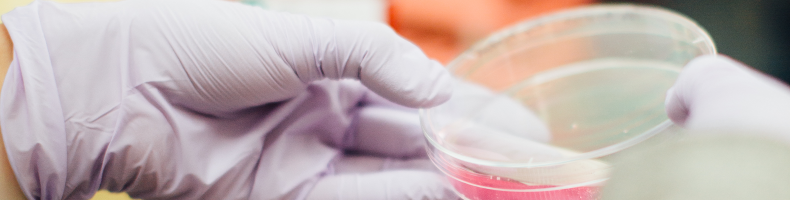

My problem with optimizer tools
Applying optimizations within a VDI environment is nowadays the de facto standard. There are different tools available to help you apply optimizations according to best practices. These optimizer tools are useful but also have a downside. In this ...
Ruthless updating within the virtual workspace
Nowadays, software companies are continuously pushing new releases (for example Microsoft with Windows 10). These releases result in a constant change process within the organization. In theory, these updates contain new functionalities and improv...
IT Pro's Perspective of Automation in 2020
Almost every IT Pro is doing some kind of automation. This is because automation helps to be consistent, efficient and avoids making mistakes. The IT industry is continuously changing and this is affecting the way we automate. But how will we auto...
Capturing Citrix XenServer performance data with PowerShell
Capturing performance data is important to fully understand the impact of changes. With automation, you can guarantee a consistent data capture which is important to compare different scenarios. In this blog post, I’m going to share how to capture...
How to capture NVIDIA GRID and Tesla performance data
When researching new technologies in a virtual desktop scenario it is very important to understand what is going on. Capturing performance data is crucial to do proper analysis and to fully understand the impact of your scenario. In this blog post...
UPDATE: App-V application was unable to start correctly on Windows 10
A couple weeks ago I received an email regarding an issue with App-V packages unable to start correctly on the latest version of Windows 10 (Creators Update, build 1703). When App-V packages are removed and added it won’t start and produces an err...
Continuous deployment with Visual Studio Team Services
In many organizations releasing a new version of a product is a hassle. Many actions and people are required to get this new version online. By using the continuous deployment techniques you can automate this entire flow. In this blog post I will ...
App-V automatically cleanup unpublished packages
With the release of Microsoft’s Creators Update (1703) new features have been added to App-V. These new features are summarized on this page. One of the new functionalities is the automatically cleanup unpublished packages and in this blog post, I...
Prototype vs Minimum Viable Product (MVP)
Gathering feedback on your new idea is very important to shape your product. During the development of your product, you probably encounter problems or have the need to validate a concept. By creating prototypes you can validate this yourself or e...
Is Windows 10 suitable for enterprises?
With the introduction of Windows 10 Microsoft has decided to change the servicing strategy. This new strategy has a more continuous delivery approach with bigger feature updates every 6 months. Many enterprise organizations are investigating the m...
 Ryan Ververs-Bijkerk
Ryan Ververs-Bijkerk